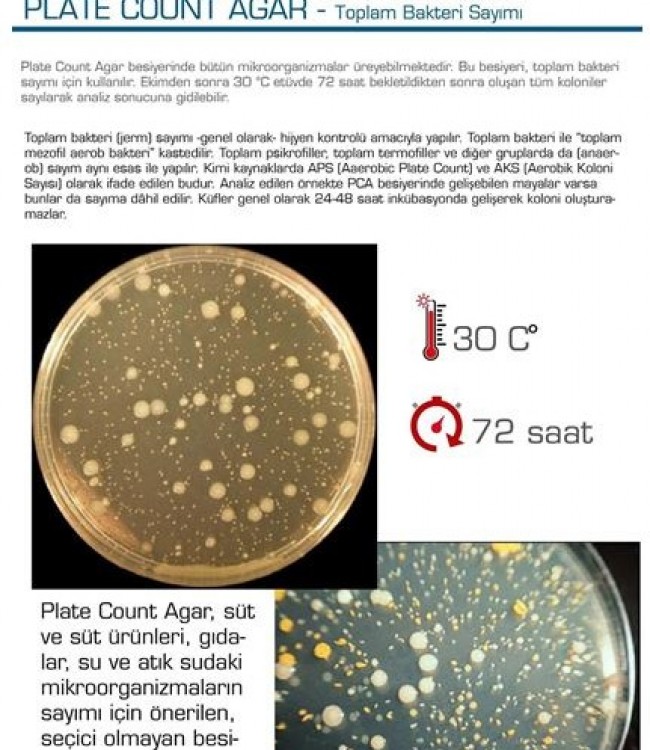
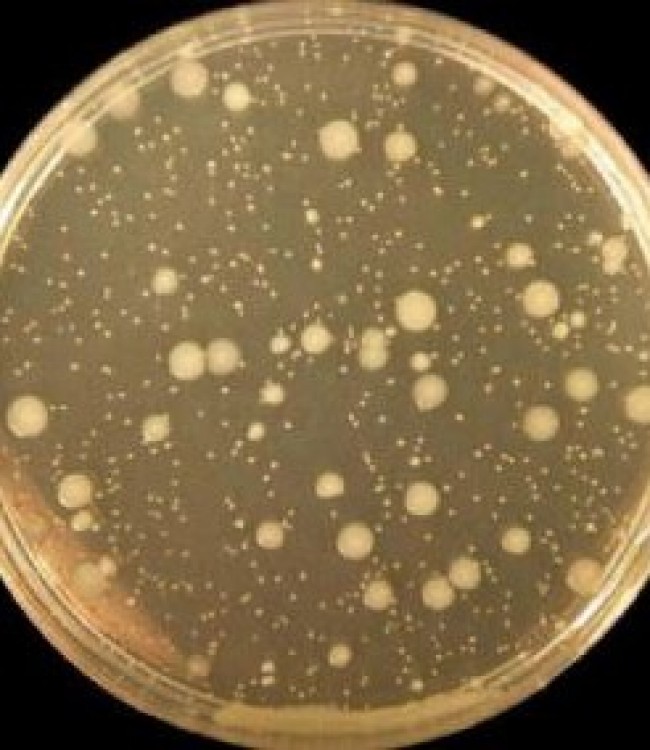

Plate Count Agar - Toplam Bakteri Sayımı
PLATE COUNT AGAR - Toplam Bakteri Sayımı
Plate Count Agar besiyerinde bütün mikroorganizmalar üreyebilmektedir.
Bu besiyeri, toplam bakteri sayımı için kullanılır.
Ekimden sonra 30 C etüvde 72 saat bekletildikten sonra oluşan tüm koloniler
sayılarak analiz sonucuna gidilebilir.
Toplam bakteri [jerm] sayımı —genel olarak— hijyen kontrolü amacıyla yapılır. Toplam bakteri ile ”toplam mezofil aerob bakteri" kastedilir
Toplam psikrofiller, toplam termofiller ve diğer gruplarda da [anaerob] sayım aynı esas ile yapılır.
Kimi kaynaklarda APS [Aaerobio Plate Count] ve AKS [Aerobik Koloni
Sayısı] olarak ifade edilen budur.
Analiz edilen örnekte PCA besiyerinde gelişebilen mayalar varsa bunlar da sayıma dâhil edilir.
Küfler genel olarak 24-48 saat inkübasyonda gelişerek koloni oluşturamazlar.
Plate Count Agar.
- Süt ve süt ürünleri
- gıdalar,
- su ve atık sudaki mikroorganizmaların sayımı için
Önerilen seçici olmayan besiyeridir.